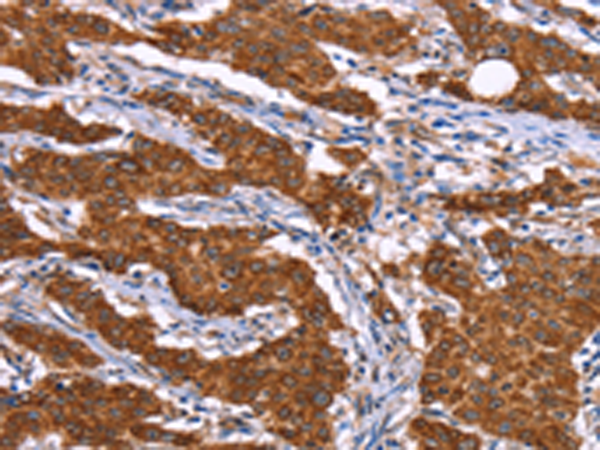
一抗

中文名稱: 兔抗RPS6KA6多克隆抗體
英文名稱: Anti-RPS6KA6 rabbit polyclonal antibody
別 名: RSK4; PP90RSK4
相關(guān)類別: 一抗
儲 存: 冷凍(-20℃)
宿 主: Rabbit
抗 原: RPS6KA6
標 記 物: Unconjugate
克隆類型: rabbit polyclonal
技術(shù)規(guī)格
|
Background: |
This gene encodes a member of ribosomal S6 kinase family, serine-threonine protein kinases which are regulated by growth factors. The encoded protein may be distinct from other members of this family, however, as studies suggest it is not growth factor dependent and may not participate in the same signaling pathways. |
|
Applications: |
ELISA, IHC |
|
Name of antibody: |
RPS6KA6 |
|
Immunogen: |
Synthetic peptide of human RPS6KA6 |
|
Full name: |
ribosomal protein S6 kinase, 90kDa, polypeptide 6 |
|
Synonyms: |
RSK4; PP90RSK4 |
|
SwissProt: |
Q9UK32 |
|
IHC positive control: |
Human gastric cancer and human thyroid cancer |
|
IHC Recommend dilution: |
25-100 |

 購物車
購物車 幫助
幫助
 021-54845833/15800441009
021-54845833/15800441009